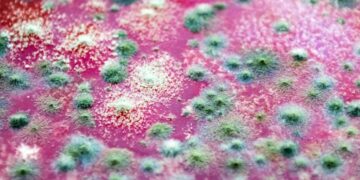
Deadly Frog Fungus Devastating Amphibians Worldwide Traced Back to Brazil

Gloria Gaynor, Mark Wahlberg, Donnie Wahlberg Getty Photographs(3)
Gloria Gaynor as soon as was left starstruck by Mark Wahlberg — though she thought she was speaking to his brother Donnie Wahlberg at first.
“My most starstruck second was assembly Mark Wahlberg,” Gaynor, 81, reveals solely in her 25 Issues You Don’t Know About Me function within the latest issue of Us Weekly, on newsstands now. “He was personable and pleasant, particularly after he realized I mistakenly thought he was his brother Donnie Wahlberg.”
The legendary singer — whose biopic Robin Roberts Presents I Will Survive: The Gloria Gaynor Story premieres on Lifetime Saturday, February 8, at 8 p.m. ET — has rubbed elbows with multiple film star in her decades-long profession.
“Gerard Butler is probably the most well-known particular person in my telephone e-book,” she revealed to Us.
For extra enjoyable tales from Gaynor, together with her proudest profession second, preserve scrolling:
1. Listening to Gospel music is my favourite strategy to get myself in a very good temper as a result of it jogs my memory of the goodness, mercy and charm of God.
2. My go-to quick meals order is 2 [chicken] thighs, French fries, coleslaw and a biscuit from Popeyes.
3. One factor I’m excited for individuals to be taught from my biopic is that I’m not a one-hit surprise and have recorded 20 albums.

Gloria Gaynor Dia Dipasupil/Getty Photographs for Tribeca Pageant
4. My favourite track that I’ve recorded is “I Will Survive” as a result of it blesses my viewers.
5. David [Nelson] from The Adventures of Ozzie and Harriet was my celeb crush rising up.
6. My favourite exercise is CrossFit, which entails completely different muscle strengthening.
7. My favourite e-book is Extra Than a Carpenter.
8. To decompress after an extended day, I examine the Bible. Proverbs Chapter 3, Verses 5 and 6 are my favourite passages.
9. The three singers I regarded as much as after I was [young] have been Nancy Wilson, Nat King Cole and Frank Sinatra.
10. The proudest second of my profession was having “I Will Survive” acknowledged within the Nationwide Recording Registry on the Library of Congress in 2016.
11. My first job was as a gross sales auditor at Bamberger’s Division Retailer.
12. The Lengthy Kiss Goodnight is my favourite film.
13. I accumulate teapots that don’t appear to be teapots and I’ve one that appears like Santa Claus.
14. Scrabble is the app I exploit probably the most. My highest rating is 420.
15. My secret expertise is stitching. I used to stitch all of my stage garments, and my favourite one which I made is a fuchsia, sequin crepe-backed satin robe.
16. Myrtle Seashore is my favourite place to trip. Once I’m there, I like going to Aquino’s Japanese Steakhouse.

Gloria Gaynor Mariano Regidor/Redferns/Getty Photographs
17. “Willow Weep for Me” brings again the most effective recollections as a result of my mother requested me to sing it at a time I didn’t even understand she knew I might sing.
18. My favourite strategy to spend the weekend is by ordering meals and binge-watching my favourite sequence. Proper now, I’m watching The Equalizer.
19. My most starstruck second was assembly Mark Wahlberg. He was personable and pleasant, particularly after he realized I mistakenly thought he was his brother Donnie Wahlberg.
20. My first automotive was a Chevrolet Monza. My favourite reminiscence is driving to my inspection and telling my husband that my automotive doesn’t have a stereo, increase field audio system [or] a CD participant — it’s [just] a automotive, and takes me the place I must go!
21. Gerard Butler is probably the most well-known particular person in my telephone e-book.
22. My favourite consolation meal is fried rooster wings, cornbread and Brussels sprouts.
23. Kissing is my favourite Valentine’s Day exercise.
24. Math was my greatest topic at school, and my alternate career could be a instructor.
25. The one merchandise left on my bucket checklist is seeing the northern lights.